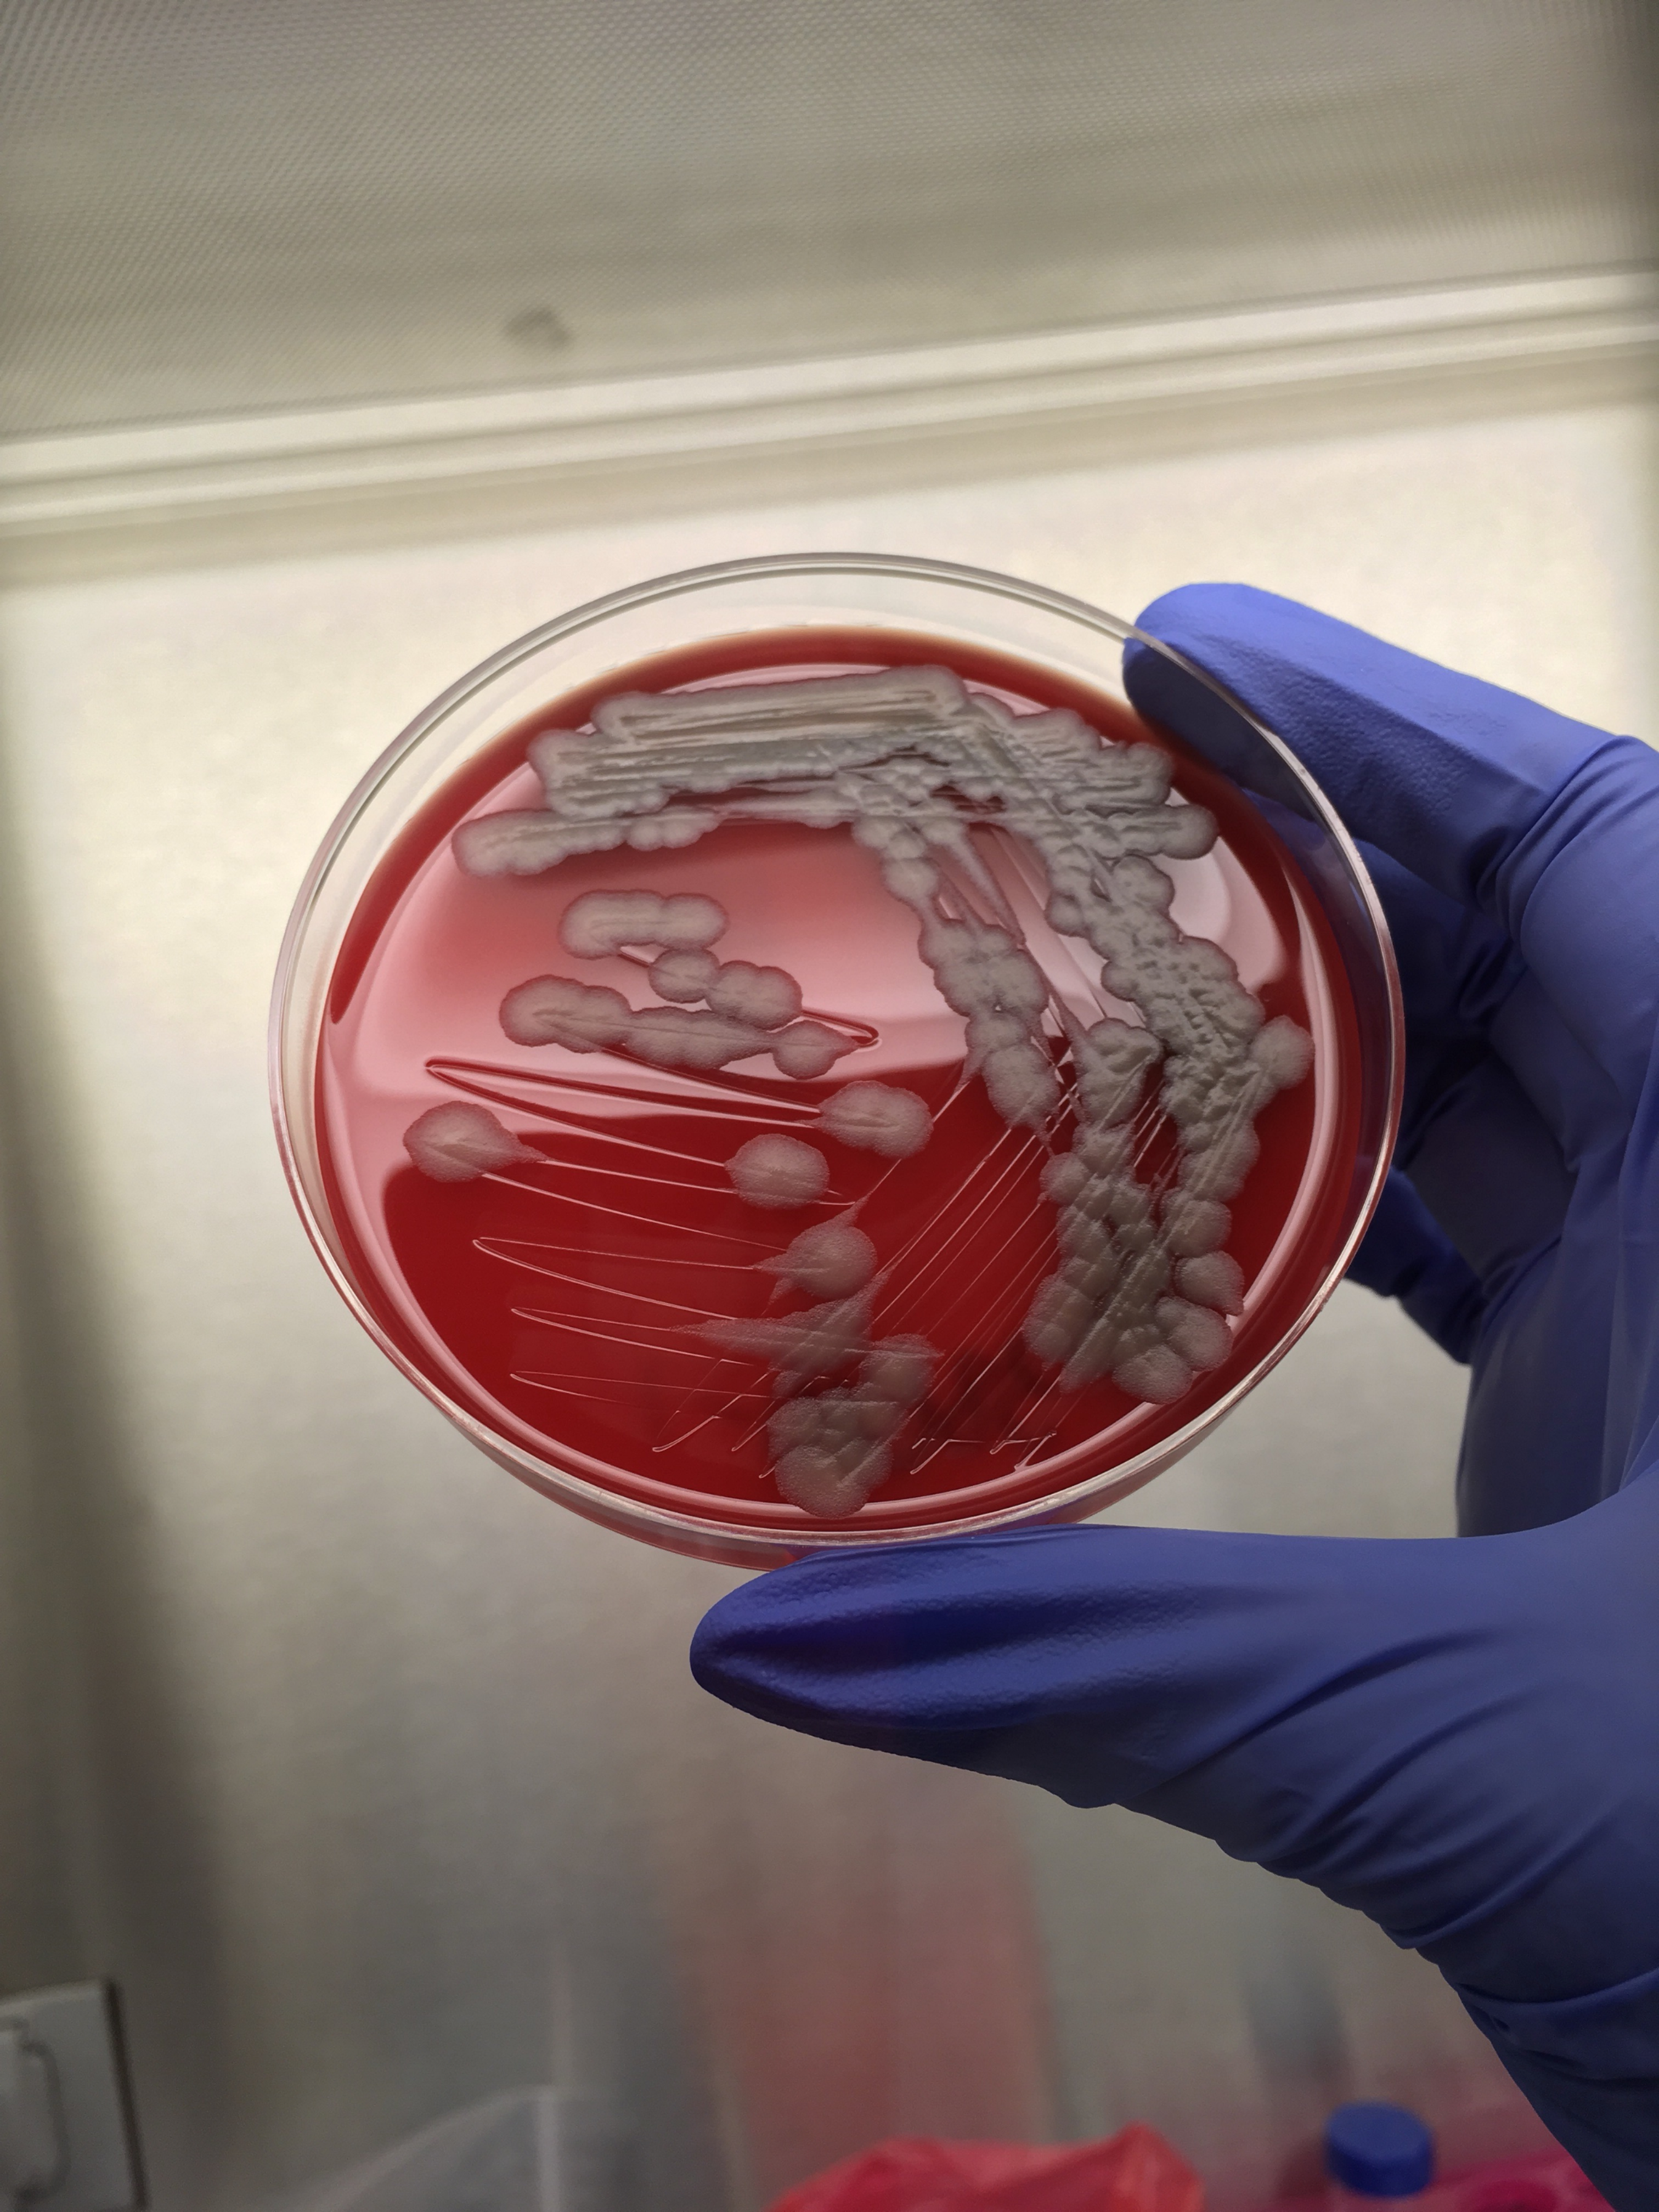

Nowadays, many people associate anthrax with bioterrorism.
Indeed, the anthrax bacteria is “one of the biological agents most likely to be used” in terrorism, according to the Centers for Disease Control and Prevention, because microscopic anthrax spores can be produced in a lab and be put into powders, sprays, food and water.
But that’s only part of the anthrax profile. The bacteria occur naturally in soil all over the world. Livestock and wildlife — such as cattle, pigs, goats and deer — can pick up the bacteria as they breathe and graze in grasslands. The bacteria can be transmitted to humans as well — absorbed through a cut in the skin, for example, when slaughtering animals, or from eating infected meat that wasn’t cooked at high-enough temperatures.
And there’s a lot we don’t know about the risks posed by anthrax in nature — notably, how many animal and human cases there are each year. Continue reading at NPR.
Categories: Freelance Articles





